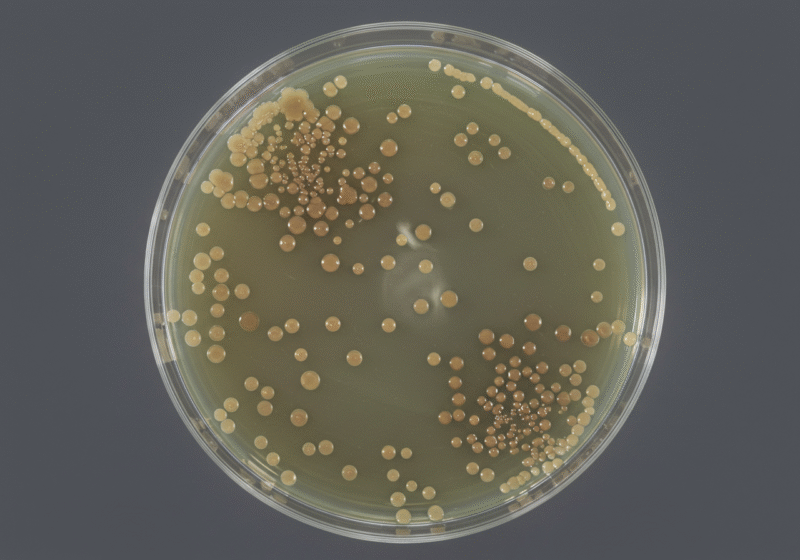

医療性物質生成器【品番60MG】


60MG 製品スペック
放電方式:無声放電方式
マテリアル:難燃性ABS(UL94V-0)
区分:医療用物質生成器
電源:AC100V(経産省へPSE認証済)
重量:1650g
外寸サイズ:W320×H100×D225
マイナスイオン濃度:≒6000万個ion/㎤
発生オゾン濃度:0.05ppm以下
第三者機関による製品試験エビデンス(株式会社食環境衛生研究所, 試験番号217298N-2)
◆ 試験目的
空気清浄装置「プラズマラボ 60MG」のインフルエンザウイルス(swine influenza virus H1N1 IOWA株)に対する不活化性能の評価。
◆ 実験設定
試験環境:1㎥チャンバー、ネブライザーにより浮遊ウイルスを生成
評価指標:TCID₅₀法による感染価測定
試験区分
- 対照区(無処理)
- 試験区1(オゾンのみ)
- 試験区2(オゾン+イオン併用)
| 処理時間 | 試験区1:オゾンのみ | 試験区2:オゾン+イオン併用 |
|---|---|---|
| 0分 | 10⁵.3 | 10⁵.3 |
| 60分 | 10⁴.3(減少率 0%) | 10².5(減少率 98.4%) |
| 120分 | 10³.5(減少率 74.9%) | 10¹.7(減少率 98.4%) |
| 180分 | 10².3(減少率 96.0%) | <10¹.5(減少率 >96.0%) |

◆ 考察(オゾンとイオンの併用の不活化効果)
オゾン単独では時間経過に伴い漸進的な減衰が確認された一方、オゾン+イオン併用では60分以内に即効的なウイルス不活化効果を示した。本データは、オゾンとイオンの併用がウイルス不活化において明確な相乗効果を持つことを実証的に裏付ける。
学術文献における科学的検証(谷村泰宏, 2003)抜粋
◆研究目的
オゾンおよびマイナスイオン(以下、負イオン)を併用した混合ガスによる微生物殺菌効果の有効性を明らかにするための基礎および実証的検証。
◆実験概要(対象微生物)
- Escherichia coli(大腸菌)
- Aspergillus niger(黒麹カビ)
処理条件
- 負イオン濃度:最大 3×10⁶ ions/cm³
- オゾン濃度:最大 0.05 ppm
実験環境(チャンバー内処理(12L)、温度20℃、湿度90%)
評価方法:生存率の測定(菌体塗布シャーレに対する時間経過による殺菌効果)
◆ 主な結果と考察
- 殺菌効果の相乗性
負イオン単独では静菌効果のみ(微生物の増殖抑制)
オゾン単独よりも負イオン+オゾンの併用の方が殺菌効果が顕著に高い。
処理時間の延長とともに生存率は指数関数的に低下。 - 濃度依存性
負イオン濃度が10³ ions/cm³以下ではほとんど殺菌効果が認められない。負イオンが10⁶ ions/cm³以上、かつオゾン濃度が0.03 ppm以上のとき、大腸菌・黒麹カビの生存率はいずれも10%未満に減少。 - メカニズム的知見
オゾンは細胞膜や蛋白質に対する酸化作用を持ち、即効的な殺菌を担う。負イオンは酸素アニオン(O₂⁻)などを含み、酸化的作用に加え、浮遊粒子の凝集沈降作用など空間制御機能も兼ね備える。両者の併用により、酸化的ストレスと粒子制御の相乗的な殺菌作用が実現される。
商用の食品貯蔵設備や空間除菌用途において、実用的かつ安全性の高い殺菌・防黴技術としての有望性が示された。
■浮遊ウイルスを99.9%不活化
上記のように2種類のプラズマを混合させた『ブースター除菌効果』で、一般のオゾン空気清浄機の10数倍の速さでウイルスを99.9%不活化。
60MGの使用方法

- 60MGの電源プラグをコンセントに差し込みます。
- 本体の上部にあるボタンを左側から順番に押してください。
- 電源ボタン(ファン駆動開始ボタン):一番左
- マイナスイオンボタン:真ん中のボタン
- オゾンボタン:一番右
- オゾン調節ダイヤル;右側面
